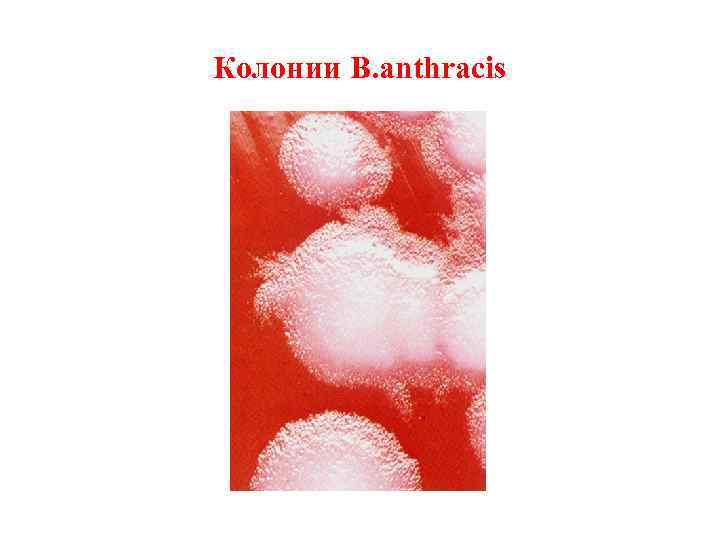
Колонии B. anthracis
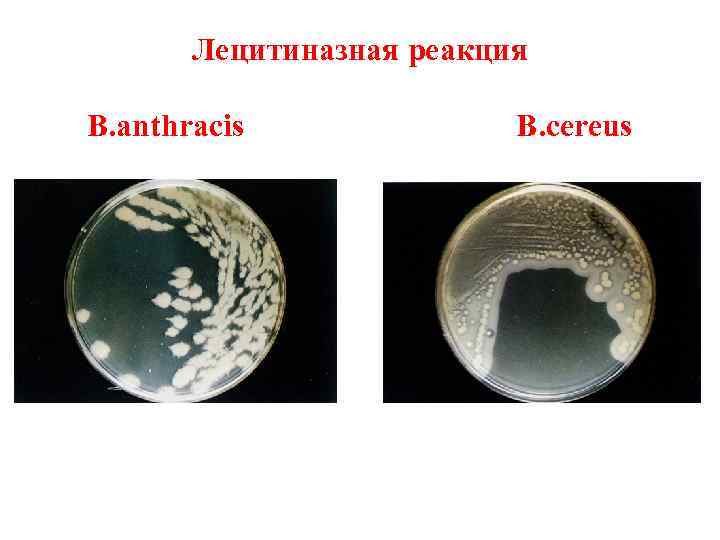
Лецитиназная реакция B. anthracis B. cereus

Возбудители зоонозных инфекций.ppt
- Количество слайдов: 34

ПАТОГЕННЫЕ АКТИНОМИЦЕТЫ. ВОЗБУДИТЕЛИ ЗООНОЗНЫХ ИНФЕКЦИЙ

План лекции • • Характеристика возбудителей актиномикозов. Общие черты и классификация зоонозных инфекций. Характеристика возбудителя чумы. Характеристика возбудителя туляремии. Характеристика возбудителей бруцеллёза. Характеристика возбудителя сибирской язвы. Характеристика возбудителя листериоза.

Морфология Actynomyces israelii Чистая культура Друза

Колонии Actynomyces israelii

Возбудители бактериальных зоонозных инфекций Возбудители Заболевания Yersinia pestis Чума Yersinia pseudotuberculosis Псевдотуберкулёз Yersinia enterocolitica Кишечный иерсиниоз Brucella melitensis, B. abortus, B. suis Бруцеллёз Francisella tularensis Туляремия Bacillus anthracis Сибирская язва Burkholderia mallei Сап Pasteurella multocida Пастереллёз Leptospira interrogans Лептоспироз Listeria monocytogenes Листериоз Chlamydophila psittaci Пневмония Coxiella burnetii Пневмония Spirillum minus Содоку Streptobacillus moniliformis Лихорадка от укуса крысы Erysipelothrix rhusiopathiae Эризипелоид Bartonella henselae Болезнь кошачьей царапины

Общие черты зоонозных инфекций • Источником инфекции являются животные. • Большинство зоонозов являются природноочаговыми заболеваниями. • Отсутствие органного тропизма у возбудителей (способны поражать практически любой орган и любую ткань). • Эпидемиология зоонозов характеризуется множеством механизмов, путей и факторов передачи. • Возбудители зоонозов являются полипатогенными микробами (способны поражать большое количество различных видов животных). • Инфекциям присущ профессиональный характер. • Тяжёлое течение заболевания с высокой летальностью.

Классификация зоонозов • Передаваемые от домашних и синантропных животных (сибирская язва, бруцеллёз, лептоспироз, сап, мелиоидоз, орнитоз, ящур, и др. ). • Передаваемые от диких животных – природноочаговые зоонозы (чума, туляремия, листериоз, клещевые спирохетозы, риккетсиозы, геморрагические лихорадки, вирусные энцефалиты и др. ).

МОРФОЛОГИЯ YERSINIA PESTIS

Бубонная чума

Микробиологическое исследование при чуме I этап Гной из бубонов, мокрота, кровь, патологоанатомический материал Бактериоскопическое исследование Мазок, окраска по методу Грама, метиленовым синим, по методу Романовского-Гимзы и др. Ориентировочное заключение Биопроба (редко) Экспресс-методы диагностики Иммунохимические исследования: иммунофлюоресцентная микроскопия, ИФА, РНГА и др. Биохимические и молекулярнобиологические исследования: ПЦР, ДНК-зонды Предварительный ответ Бактериологическое исследование Первичный посев на плотные элективные и дифференциально-диагностические среды для получения изолированных колоний (инкубация при 280 С)

Микробиологическое исследование при чуме II этап Учёт результатов посева Культуральные признаки: морфология колоний Мазок, окраска по методу Грама Серологическая идентификация: РА с противочумной сывороткой Пересев типичных колоний на плотные среды (получение чистой культуры) Предварительный ответ

Микробиологическое исследование при чуме III этап Определение чувствительности к антибиотикам Идентификация чистой культуры Мазок, окраска по методу Грама По биохимически м признакам: посев на «пёстрый» ряд Серологическая идентификация По чувствительности к чумному бактериофагу Окончательный ответ Биохимические и молекулярнобиологические методы идентификации: ПЦР, ДНК-зонды

Основные отличительные признаки Y. pestis по сравнению с Y. pseudotuberculosis • • Антигенные свойства. Подвижность (Y. pseudotuberculosis подвижна). Чувствительность к чумному бактериофагу. Ферментация рамнозы (Y. pestis не ферментируют).

МОРФОЛОГИЯ FRANCISELLA TULARENSIS (окраска по Романовскому-Гимзе)

ФАКТОРЫ ВИРУЛЕНТНОСТИ FRANCISELLA TULARENSIS

Микробиологическое исследование при туляремии I этап Гной из бубона, пунктат лимфатических узлов, мокрота, кровь, патологоанатомический материал Биопроба редко Бактериологическое исследование Экспресс-методы диагностики Сыворотка крови Серодиагностика Заражение мышей, морских свинок Иммунохимичес- Биохимические исследова- кие и молекуния: иммуно- лярно-биолофлюоресцентная гические исмикроскопия, следования: ИФА, РНГА и др. ПЦР Предварительный ответ Посев на плотные элективные среды обогащения для получения изолированных колоний РА, РНГА, ИФА и др. Ответ Кожноаллергическая проба с тулярином Ответ

Микробиологическое исследование при туляремии II-III этапы Учёт результатов посева Культуральные признаки: морфология колоний Мазок, окраска по методу Грама Серологическая идентификация: РА с противотуляремийной сывороткой Предварительный ответ Пересев типичных колоний на плотные среды (получение чистой культуры) Идентификация чистой культуры Мазок, окраска по методу Грама По биохимическим признакам: посев на «пёстрый» ряд Серологическая идентификация Биохимические и молекулярно-биологические методы идентификации: ПЦР, ДНК-зонды Окончательный ответ Определение чувствительности к антибиотикам

ВИДЫ БРУЦЕЛЛ И ВЫЗЫВАЕМЫЕ ИМИ ЗАБОЛЕВАНИЯ

МОРФОЛОГИЯ BRUCELLA MELITENSIS (окраска по Граму)

КОЛОНИИ BRUCELLA ABORTUS (сывороточно-декстрозный агар)

Микробиологическое исследование при бруцеллёзе I этап Кровь Биопроба Заражение мышей, морских свинок Сыворотка крови Бактериологическое исследование Экспрессметоды диагностики Биохимические и молекулярно-биологические исследования: ПЦР Предварительный ответ Посев на жидкие элективные среды обогащения Посев на плотные элективные среды обогащения для получения изолированных колоний Серодиагностика РА, РНГА, ИФА и др. Ответ Кожноаллергическая проба с бруцеллином Ответ

Микробиологическое исследование при бруцеллёзе II-III этапы Учёт результатов посева Культуральные признаки: морфология колоний Мазок, окраска по методу Грама Серологическая идентификация: РА с противобруцеллёзной сывороткой Предварительный ответ Пересев типичных колоний на плотные среды (получение чистой культуры) Идентификация чистой культуры Мазок, окраска по методу Грама По биохимическим признакам: посев на «пёстрый» ряд Серологическая идентификация Биохимические и молекулярно-биологические методы идентификации: ПЦР, ДНК-зонды Окончательный ответ Определение чувствительности к антибиотикам

Кольцевая проба Банга

МОРФОЛОГИЯ BACILLUS ANTHRACIS Окр. по Ауеске РИФ Капсула (в органах)
Колонии B. anthracis

Кожная форма сибирской язвы

ФАКТОРЫ ВИРУЛЕНТНОСТИ BACILLUS ANTHRACIS

Микробиологическое исследование при сибирской язве I этап Экссудат из очага поражения, мокрота, испражнения, кровь Бактериоскопическое исследование Мазок, окраска по методу Грама Ориентировочное заключение Посев крови на основные жидкие среды обогащения Потенциально инфицированное сырьё животного происхождения Бактериологическое исследование Экспресс-методы диагностики Иммунохимические исследования: иммунофлюоресцентная микроскопия, ИФА и др. Биохимические и молекулярно-биологические исследования: ПЦР Предварительный ответ Посев на плотные среды (кровяной агар и др. ) для получения изолированных колоний Биопроба Заражение мышей, кроликов, морских свинок Кожноаллергическая проба с антраксином Ответ

Микробиологическое исследование при сибирской язве II-III этапы Учёт результатов посева Мазок, окраска по методу Грама Культуральные признаки: морфология колоний, гемолитическая активность Предварительный ответ Пересев типичных колоний на плотные среды (получение чистой культуры) Определение чувствительности к антибиотикам Идентификация чистой культуры По культуральным признакам По биохимическим признакам: посев на «пёстрый» ряд. По чувствительности к бактериофагу Биохимические и молекулярно -биологические методы идентификации: ПЦР, ДНКзонды. Окончательный ответ
Лецитиназная реакция B. anthracis B. cereus

Тест «жемчужного ожерелья» при культивировании B. anthracis на агаре с пенициллином (справа)

МОРФОЛОГИЯ BACILLUS CEREUS Окр. по Ауеске Окр. метиленовым синим Электронограмма

ФАКТОРЫ ВИРУЛЕНТНОСТИ BACILLUS CEREUS

КОЛОНИИ L. MONOCYTOGENES (смешанная культура)
Возбудители зоонозных инфекций.ppt